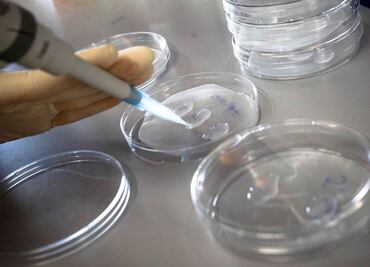
Tejido fetal, esencial para investigaciones: científicos

Resultados serán útiles para avanzar en investigación de cáncer, y estudio de enfermedades neurodegenerativas

Resultados serán útiles para avanzar en investigación de cáncer, y estudio de enfermedades neurodegenerativas

La idea es cultivar las células en enormes cantidades para después introducirlas en el cuerpo del enfermo

Células en las que se encuentra este tipo de proteína no infectan a las células sanas del individuo

Siguen el paso de las estaciones del año

Tiene una capacidad limitada para repararse tras una pérdida sustancial de células musculares

Es el cáncer más común entre las mujeres
Científicos los emplean para crear vacunas y tratar enfermedades

Permite transformar células adultas en células madre

Laboratorio empleará células pluripotentes inducidas que tienen capacidad para convertirse en cualquier tipo de tejido

Se podría regenerar tejido humano o incluso crear órganos o vasos sanguíneos